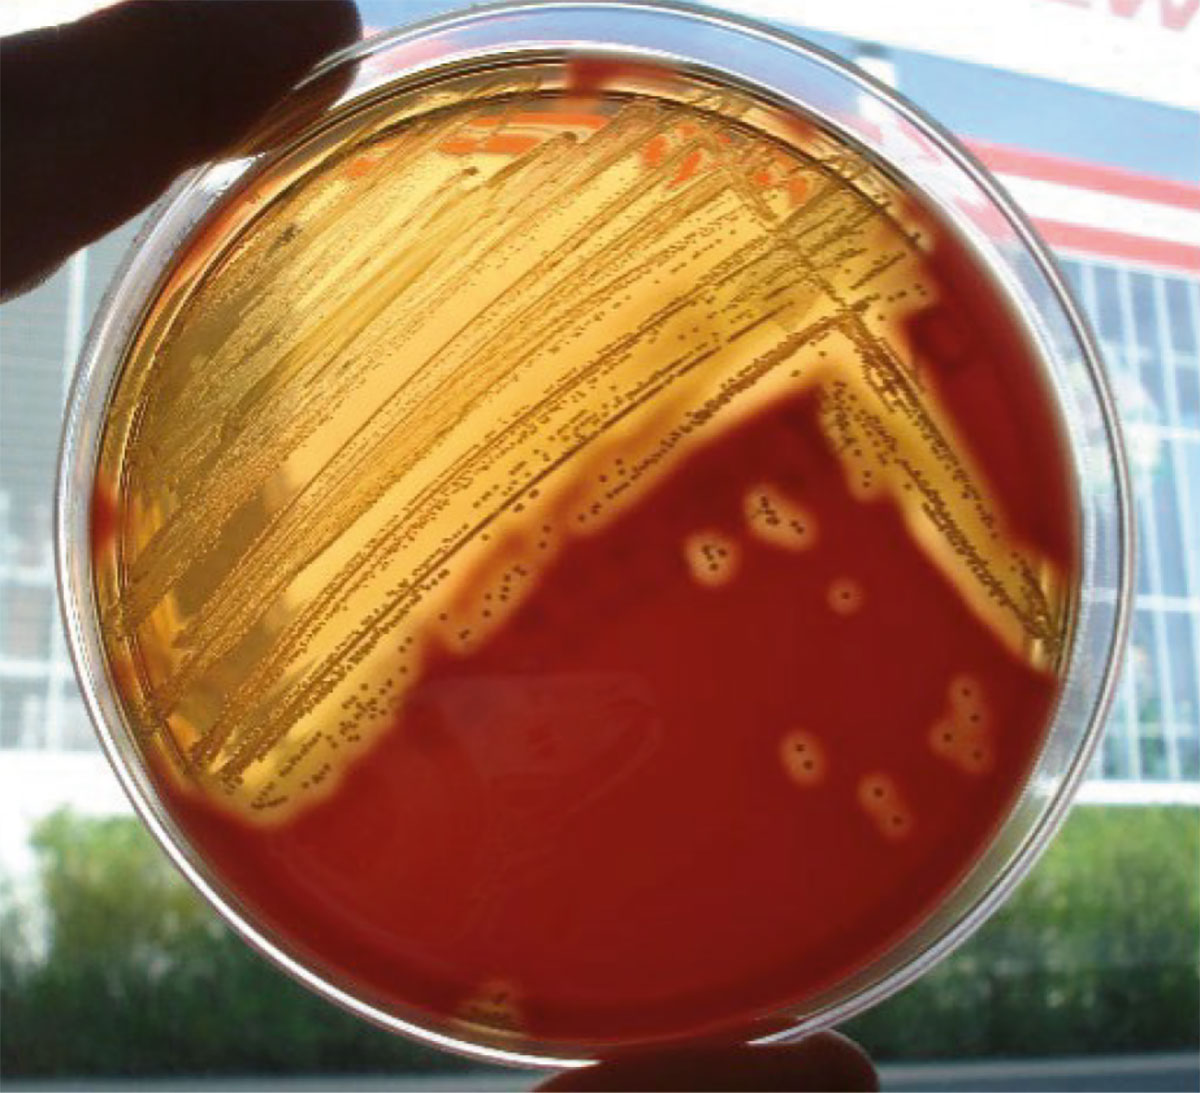

Igiene nella riproduzione
Indicazioni e raccolta del campione
I problemi di fertilità nelle cavalle possono essere causati dalla colonizzazione batterica degli organi genitali. Durante l’accoppiamento naturale, i batteri possono poi causare infezioni nello stallone. Per una buona fertilità, l’utero e la cervice devono essere privi di germi patogeni.
Ciò richiede un esame batteriologico ed eventualmente anche micologico di un campione prelevato con un tampone il più sterile possibile.
Nelle cavalle che hanno partorito un puledro sano, dopo un parto avvenuto senza problemi, e che non hanno segni clinici di infezione genitale, così come nelle cavalle di tre anni che non si sono mai accoppiate, si può presumere che di norma nell’utero non siano presenti germi che potrebbero comprometterne la fertilità. In questi casi viene omesso l’esame batteriologico, che però viene spesso richiesto dal proprietario dello stallone in caso di monta naturale.
L’esame colturale è obbligatorio se:
- le cavalle non sono state coperte o inseminate nell’anno precedente o se queste sono rimaste vuote;
- sono presenti segni clinici di malattia genitale;
- le cavalle hanno abortito;
- il parto e l’espulsione della placenta non sono avvenuti normalmente;
- le fattrici sono state coperte/inseminate due volte durante l’attuale stagione riproduttiva.
Prima di effettuare un tampone è sempre necessario escludere una gravidanza in corso! Il momento ideale è durante l’estro, quando la cervice è aperta. Per un risultato batteriologico significativo è molto importante che il tampone non entri in contatto con la cute, il vestibolo vaginale o la mucosa vaginale. In queste aree possono annidarsi germi che non si trovano nell’utero.
In ogni caso, per ottenere risultati più significativi possibili, il campione deve essere prelevato utilizzando uno speculum.
Quando si preleva un campione utilizzando uno speculum, è possibile esaminare la mucosa vaginale per individuare eventuali segni di infiammazione o di depositi.
Igiene della riproduzione: referti batteriologici
I seguenti batteri vengono classificati come patogeni durante gli esami di igiene della riproduzione. Il trattamento è raccomandato anche nelle cavalle clinicamente sane prima dell’accoppiamento:
- Streptococchi β-emolitici
- Staphylococcus aureus
- Escherichia coli haemolytica
- Pseudomonas aeruginosa
- Klebsiella
- Raoultella ornithinolytica (precedentemente: Klebsiella ornithinolytica)
- Actinobacillus equuli
- Bordetella bronchiseptica
- Rhodococcus hoagii (precedentemente noto come equi)
- Immagine: Envato Elements
-
Fig. 1: Percentuale di batteri patogeni rilevati nella coltura per
l’igiene della riproduzione (cavallo)
Immagine: Laboklin
-
Fig. 2: Streptococchi ß-emolitici su agar sangue
Immagine: Laboklin
-
Fig. 3: Percentuale di rilevamento di lieviti e muffe nella coltura micologica.
Immagine: Laboklin
La differenziazione dei germi viene eseguita in base alla morfologia della coltura e al MALDI-TOF.
Anche in presenza di Escherichia coli senza emolisi si raccomanda il trattamento prima dell’accoppiamento se il numero rilevato di questi era elevato di e se la coltura era pura. I risultati microbiologici devono sempre essere valutati insieme ai cambiamenti clinici durante la visita ginecologica.
In questi casi, il veterinario curante decide se autorizzare la riproduzione della cavalla o se adottare le misure necessarie, come una terapia o un periodo di attesa.
Se vengono rilevati germi rilevanti per l’igiene della riproduzione, viene preparato un antibiogramma utilizzando il metodo della microdiluizione.
Altri batteri considerati non specifici sono indicati nel referto, ma non viene eseguito alcun antibiogramma.
L’esame batteriologico di solito dura solitamente 2 – 3 giorni, compreso l’antibiogramma.
Sono stati valutati i tamponi equini inviati per il test culturale per l’igiene della riprozione nel 2021 e fino ad agosto 2022. Non erano disponibili solitamente informazioni sulla sintomatologia clinica.
In circa il 30% dei campioni analizzati sono stati rilevati germi patogeni. Tra i batteri classificati come patogeni, sono stati rilevati più frequentemente gli streptococchi β-emolitici, con il 21,79%.
Nell’1,70% dei campioni erano presenti E. coli non emolitici e nell’1,19% E. coli con proprietà emolitiche in elevate concentrazioni in coltura pura.
Sebbene lo Staphylococcus aureus sia stato solo il quarto ceppo più frequentemente rilevato, con una percentuale dello 0,81%, vale la pena notare che il 24% degli isolati era resistente alla meticillina.
Taylorella equigenitalis
La metrite contagiosa equina (CEM) è una malattia riproduttiva soggetta a denuncia, causata dal batterio Taylorella equigenitalis. Mentre gli stalloni infetti sono solitamente portatori asintomatici, nelle fattrici Taylorella equigenitalis può causare endometriti e disturbi della fertilità. Possiamo avere tuttavia anche infezioni inapparenti. Secondo la direttiva 92/65/CEE, i tamponi devono essere prelevati da almeno due punti della cavalla: dalla fossa clitoridea e dal seno clitorideo. Oltre alla coltura dei patogeni, un’altra metodologia di analisi idonea è la PCR. Indipendentemente dalla procedura, devono essere utilizzati solo tamponi con carbone attivo (Amies – mezzo di trasporto).
L’esame colturale deve iniziare entro e non oltre le 24 ore dalla raccolta del campione (48 ore dalla raccolta del campione se il trasporto avviene refrigerato). Per la PCR, non devono trascorrere più di 48 ore tra la raccolta del campione e l’inizio dell’analisi. È necessario un tampone diverso per ogni metodica.
Nei cavalli islandesi, oltre all’esame colturale per l’igiene della riproduttiva, prima dell’accoppiamento è richiesta l’esclusione colturale di Taylorella equigenitalis.
Il test colturale per Taylorella equigenitalis dura 7 giorni. La PCR offre il vantaggio di una diagnosi più rapida, entro 1-3 giorni lavorativi.
Igiene della riproduzione: referti micologici
Soprattutto se durante l’ispezione della mucosa vaginale si riscontrano depositi biancastri, si deve prendere in considerazione anche un’infezione fungina. Un’infezione grave solitamente provoca un utero molto pieno di secrezioni grigie, mucose e torbide. La mucosa cervicale e l’endometrio appaiono di colore rosso scuro-torbido e chiaramente infiammati.
Nelle colture micologiche positive sono stati rilevati più frequentemente lieviti del genere Candida. Nel nostro rilevamento, Candida parapsilosis (3,5%) era dominante in coltura pura e con un’elevata conta batterica.
Candida parapsilosis può colonizzare la pelle, la cornea e le mucose. Negli esseri umani si teme che questo agente patogeno possa causare endocardite dopo interventi di cateterizzazione.
Il fattore predisponente all’infezione da lieviti include per lo più una precedente terapia antibiotica a lungo termine, in particolare come applicazione intrauterina di antibiotici. Si sta discutendo anche dell’impiego di diluitori dello sperma contenenti antibiotici nell’inseminazione artificiale.
Tra le muffe, sono stati rilevati più frequentemente Mucor spp. e varie specie di Aspergillus, ma solitamente solo in piccole quantità. Se il numero rilevato è basso, soprattutto nel caso di muffe, è opportuno mettere in dubbio una coltura positiva e valutare se non si tratti di un segno di contaminazione.
Conclusione sull’igiene della riproduzione
Durante la stagione riproduttiva è importante valutare l’idoneità alla riproduzione di tutte le fattrici destinate alla fecondazione. Oltre alla visita ginecologica va eseguito un esame microbiologico dei tamponi uterini.
Si raccomanda di iniziare questi controlli per tempo, prima che inizi la stagione riproduttiva, in modo che anche gli animali nei quali eventualmente si rileveranno agenti patogeni, possano essere riportati in salute attraverso misure terapeutiche appropriate, senza perdere tempo prezioso.
Se il tampone risulterà positivo, il trattamento dovrà essere effettuato prima dell’accoppiamento. Il successo del trattamento potrà essere verificato con un nuovo esame batteriologico o micologico almeno 10 giorni dopo la fine della terapia. Se l’esame successivo non dovesse dare risultati significativi, l’estro successivo potrà essere utilizzato per l’accoppiamento. Con una buona gestione dell’allevamento, idealmente tutte le procedure diagnostiche e terapeutiche dovrebbero venire completate prima dell’inizio della stagione riproduttiva.
Diagnosi ormonale della gravidanza
Dopo averne appurato l’idoneità alla riproduzione, le fattrici sane possono essere sottoposte all’inseminazione o alla monta. Gli esami che accompagnano l’estro sono di natura puramente clinica: abbiamo i controlli dei follicoli mediante palpazione rettale, eventualmente con l’aggiunta di un’ecografia.
Gli esami in corso di gravidanza vengono effettuati anche tramite palpazioni rettali, integrate per lo più nelle fasi iniziali da un’ecografia. Solo in questo modo è possibile accertarsi della presenza di un feto vivo all’inizio della gravidanza e, ad esempio, escludere gravidanze gemellari.
Ma nella pratica non è sempre possibile effettuare un esame manuale. La palpazione rettale deve essere evitata nei cavalli di piccola taglia, nei pazienti non collaborativi, negli animali selvatici e da zoo oppure quando si sospettano lesioni rettali.
In questi casi può essere utilizzata la determinazione degli ormoni specifici della gravidanza, che presentano concentrazioni tipiche in fasi definite.
A questo scopo abbiamo a disposizione diversi test:
- la gonadotropina sierica della cavalla gravida (PMSG) = gonadotropina corionica equina (eCG)
- l’estrone solfato
- il progesterone
- lo shift luteo-placentare (funzionalità placentare – rapporto 5α-DHP/progesterone)
PMSG/eCG
Questo ormone viene secreto, con leggere variazioni individuali, dalle coppe endometriali approssimativamente tra il 35° e il 120° giorno di gravidanza. Si consiglia di prelevare il campione tra il 45° e il 100° giorno dopo l’ovulazione. Le concentrazioni più elevate di PMSG vengono misurate dal 60° al 75° giorno. Nelle “aree periferiche” della finestra temporale raccomandata possono verificarsi risultati dubbi, che dovranno poi essere confermati da esami di follow-up. In caso di riassorbimento fetale, che può verificarsi durante questo periodo, le coppe endometriali continueranno a produrre PMSG per settimane, anche se non ci sarà più un feto vivo. La rilevazione del PMSG sarà quindi un falso positivo. Inoltre, le cavalle colpite non mostreranno alcun estro durante questo periodo.
Estrone solfato
Questo ormone è prodotto da un’unità feto-materna intatta ed è quindi indicativo di un feto vivo. A partire dal 40° giorno di gravidanza circa, l’ormone viene secreto in concentrazioni crescenti. Tuttavia, in queste fasi iniziali, non è possibile effettuare una distinzione affidabile dalla secrezione ciclica di estrogeni.
Si consiglia di misurare l’estrone solfato a partire dal 110° giorno di gravidanza, poiché le cavalle gravide presentano concentrazioni molto più elevate dell’ormone in questo periodo. Inoltre, le cavalle precedentemente trovate gravide tramite PMSG dovrebbero ora essere testate per l’estrone solfato. Questo test può essere eseguito anche sulle urine.
Le fattrici con risultati dubbi o inconcludenti devono essere sottoposte a nuova visita dopo 3 o 4 settimane.
Se il risultato del test è negativo per le fattrici sicuramente gravide da oltre 110 giorni, potrebbero esserci danni al feto/placenta. In questo caso non si può fare a meno di una palpazione rettale o di un’ecografia.
Progesterone
Il progesterone è l’ormone del corpo luteo. Questo esame ha un senso solo tra il 18° e il 21° giorno post ovulazione – supponendo che la cavalla abbia un ciclo stabile di 21 giorni. Poiché il test non è in grado di distinguere tra corpo luteo ciclico e corpo luteo gestazionale, il rilevamento di un corpo luteo funzionante in questo momento significa solo che la cavalla non entrerà in estro nel momento previsto.
Shift luteo-placentare (funzionalità placentare – rapporto 5α-DHP/progesterone)
La determinazione del rapporto 5α-DHP / progesterone mediante la misurazione del 5α-diidroprogesterone (DHP) consente la determinazione dello shift luteo-placentare e della funzione placentare.
Lo shift luteo-placentare indica il momento della gravidanza in cui la produzione di ormoni si sposta dalle ovaie alla placenta. Questo risulta rilevante per sapere quando è il corretto periodo di integrazione progestinica nelle cavalle problematiche in gravidanze ad alto rischio o nella valutazione della funzionalità placentare nella fase avanzata della gravidanza.
Dott. Anton Heusinger, dott.ssa Antje Wöckener